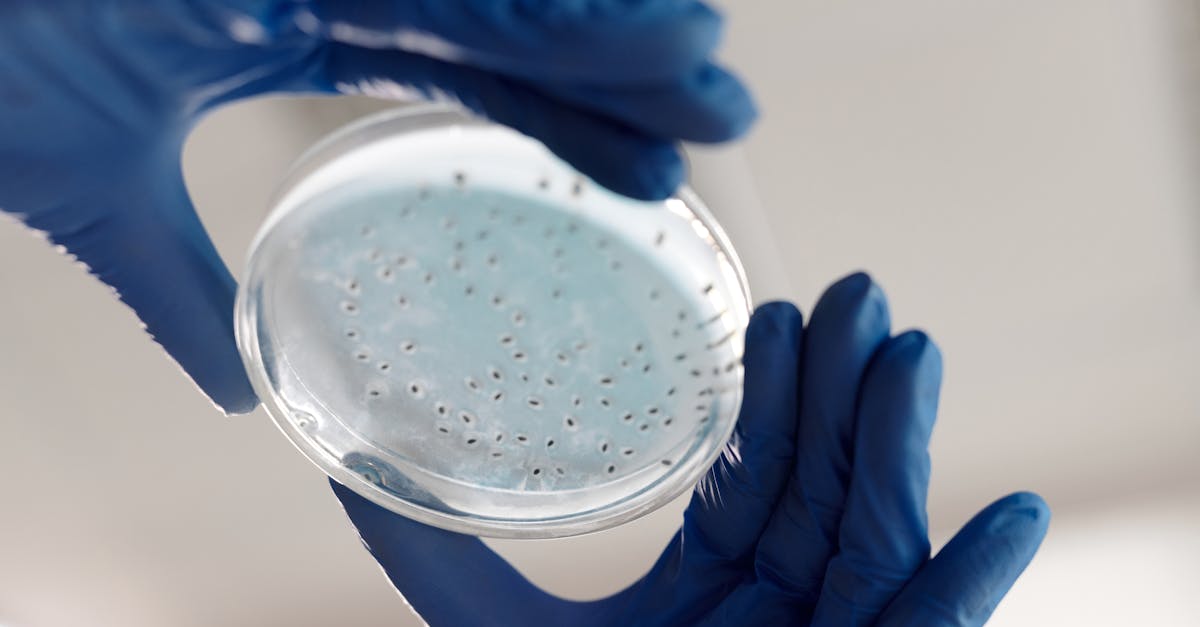

7 Mind-Bending Facts Scientists Just Confirmed
In a world constantly reshaped by scientific revelations, the latest breakthroughs have once again redefined our understanding of reality. Recent confirmations by scientists have unveiled facts that are not only astonishing but also challenge the boundaries of our knowledge. These discoveries span from the microscopic intricacies of our biological makeup to the vast expanses of the cosmos, each offering a glimpse into the mysteries that govern our existence. As we delve into these seven mind-bending facts, prepare to embark on a journey that will stretch the limits of your imagination and deepen your appreciation for the intricate tapestry of the universe.
Quantum Entanglement Across Time

One of the most perplexing phenomena in quantum physics, entanglement, has taken an even more bizarre turn with recent studies suggesting that it can occur not just across space, but time. Scientists have demonstrated that particles can become entangled in a way that defies the conventional flow of time, creating correlations between events that seem to occur in different temporal realms. This finding challenges our traditional understanding of causality, suggesting that the universe may operate on principles that allow for connections beyond our linear perception of time. Such revelations not only deepen our understanding of quantum mechanics but also open up new possibilities for futuristic technologies like time-traveling communications.
The Consciousness of Plants

Long considered passive organisms, plants have recently been shown to possess a form of consciousness that challenges our anthropocentric views. Researchers have discovered that plants can process information, respond to their environment, and even communicate with each other using chemical signals. These findings suggest that plants have a form of intelligence that allows them to adapt to their surroundings in ways previously thought impossible. This burgeoning field of study, known as plant neurobiology, is reshaping our understanding of life on Earth, suggesting that the line between sentient and non-sentient beings is far more blurred than previously believed.
The Universe's Hidden Dimensions

The concept of hidden dimensions has moved from the realm of theoretical physics to empirical science. Recent experiments at CERN have provided evidence that supports the existence of additional spatial dimensions beyond the familiar three. These hidden dimensions could explain some of the universe's most perplexing mysteries, such as the nature of dark matter and dark energy. The discovery of these dimensions not only revolutionizes our understanding of the cosmos but also has profound implications for the future of physics, potentially leading to a unified theory that reconciles quantum mechanics with general relativity.
Microbial Mind Control
Recent studies have uncovered the astonishing ability of certain microbes to influence the behavior and decision-making processes of their hosts. This phenomenon, known as microbial mind control, suggests that the microbiome within our bodies plays a far more significant role in our mental health and cognition than previously understood. Researchers have found correlations between gut bacteria and conditions such as depression, anxiety, and even schizophrenia. This discovery is prompting a reevaluation of how we approach mental health, with the potential for new treatments that target the microbiome to improve psychological well-being.
The Resilience of Life in Extreme Conditions

Life's ability to thrive in extreme conditions has been further confirmed with the discovery of organisms that can survive in environments previously thought to be uninhabitable. From the crushing pressures of the deep ocean to the scorching heat of volcanic vents, these extremophiles challenge our understanding of life's limits. Recent explorations have uncovered microbes that can withstand radiation levels lethal to humans, suggesting that life could exist in similarly extreme environments on other planets. These findings not only expand the potential for extraterrestrial life but also provide insights into the resilience and adaptability of life on Earth.
The Plasticity of Human Memory

The malleability of human memory has been further elucidated with recent studies showing how memories can be altered, erased, or even implanted. Researchers have demonstrated that memories are not static but are instead dynamic constructs that can be reshaped by new experiences and information. This plasticity poses significant implications for understanding memory-related conditions such as PTSD and Alzheimer's disease. It also raises ethical questions about the potential for memory manipulation and the nature of personal identity, as our memories are integral to our sense of self.
The Cosmic Web: A New View of the Universe

The universe has long been viewed as a collection of isolated galaxies, but recent research has confirmed the existence of a vast cosmic web that connects everything. This web, composed of dark matter and intergalactic gas, forms a complex network that influences the formation and evolution of galaxies. The discovery of this cosmic web offers a new perspective on the structure of the universe, suggesting that galaxies are not solitary islands but part of a larger interconnected system. This revelation not only transforms our understanding of cosmic architecture but also provides a framework for studying the universe's history and future.
Embracing the Unknown

As we reflect on these seven mind-bending facts, it becomes clear that the universe is far more complex and interconnected than we ever imagined. Each discovery challenges our preconceived notions and invites us to explore the unknown with curiosity and wonder. As scientists continue to unravel the mysteries of existence, we are reminded of the boundless potential for discovery that lies ahead. These revelations not only enrich our understanding of the world but also inspire us to embrace the unknown, pushing the boundaries of human knowledge in the pursuit of truth.







